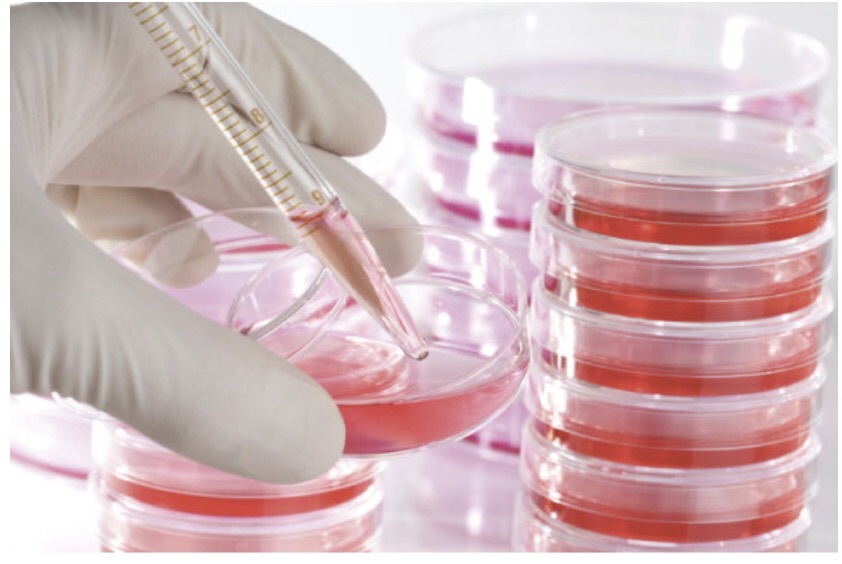

長い期間、KIYOMIシャンプーの投稿を読みながらも、なかなかご注文をする勇気が無い方もいらっしゃるようです。
でも、使ってみればこの通り♪
人それぞれに実感する部分が違うという
珍しいシャンプー&トリートメント。

この方はKIYOMIシャンプーでお身体のにおいが気にならなくなったようです。
迷ってる方は遠慮なさらずご連絡ください。
殆どの方がリピーターになってる製品ですよ。
・髪に優しい
・肌に優しい
・環境に優しい
・老若男女問わず
・肌質問わず
・髪にボリュームが欲しい人も
・髪の硬さや量を落ち着かせたい人も
・グランディングしたい人も
・頭が重い人、クリアにしたい人も

本当に万人に喜ばれている
エネルギーに満ちたシャンプー&トリートメントです!
またはLINE@をご登録の上、ご連絡ください。

 お申込・お問合せフォーム
お申込・お問合せフォーム


 Mind Body Spirit☆リセット リチャージ デトックス心から笑顔になれるセラピーサロン♡アナログ
Mind Body Spirit☆リセット リチャージ デトックス心から笑顔になれるセラピーサロン♡アナログ